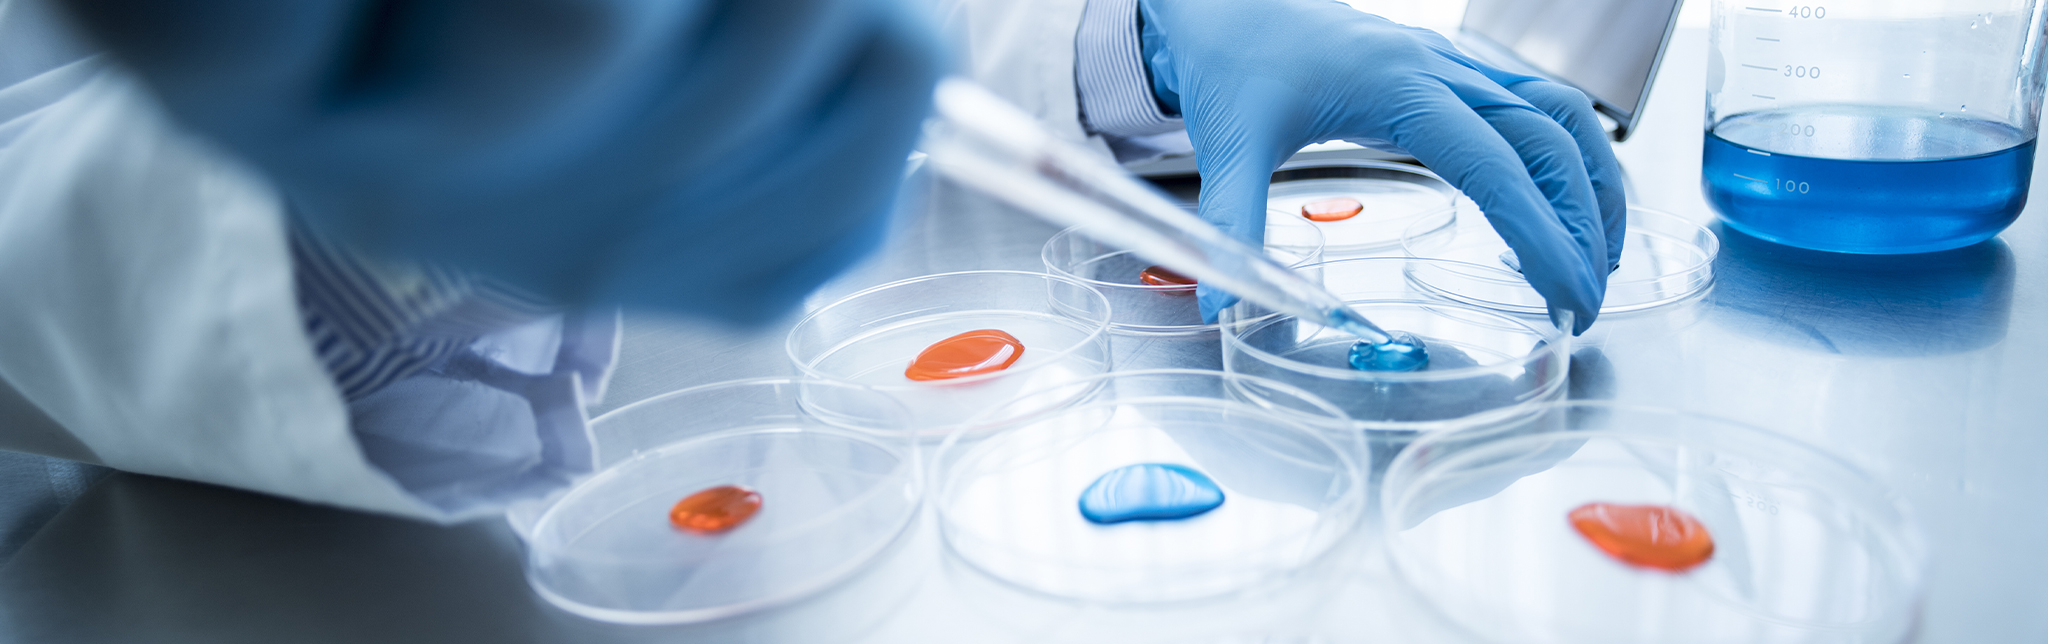

プライバシーポリシー
当社は、お客様個人を識別し得る情報(以下、「個人情報」といいます)を適切に保護することが重要であると認識し、以下のように会社として取り組んでおります。
①適切な個人情報の収集、利用、提供、預託を行います。
個人情報を本人の意思に反して収集、利用、提供、預託することは、権利の侵害になると共に事業者としての信頼を失うことになります。そのた め、個人情報の収集、利用、提供、預託等の管理ルールを明文化し、個人情報の適切な管理を行います。
お客様から個人情報を収集させていただく場合は、収集目的、当社の問合せ窓口等を明示したうえで、必要な範囲の個人情報を収集させていただきます。法的な 要請等によらない限り、お客様の事前承認なく第三者に開示・提供することはありません。また、お客様の個人情報を業務委託先に提供する場合は、守秘契約等 によって業務委託先に個人情報保護を義務付けるとともに、業務委託先が適切に個人情報を取り扱うように管理いたします。
②個人情報の紛失、破壊、改ざん、および漏えい等を防止する対策を行います。
個人情報の紛失、破壊、改ざん、および漏えい等を防止するため、不正アクセス対策、ウイルス対策等の情報セキュリティ対策を行います。
③法令およびその他の規範を遵守します。
個人情報の取り扱いに関して、個人情報保護法をはじめとする個人情報に関する法令およびその他の規範を遵守するとともに、社内規程に準拠して 行動します。また、役員を含む就業者に教育・啓発を実施します。
④個人情報保護コンプライアンス・プログラムの継続的改善を行います。
個人情報保護に関するコンプライアンス・プログラムを策定し、実施し、維持し、および継続的改善を行います。
⑤ご紹介とお問合せについて。
当社は、お客様の個人情報を、あらかじめお客様に明示した収集目的等の範囲で利用します。また、当社は、お客様にご利用いただいた当社のサー ビス、商品等に関連する情報を、電子メールまたは送付物によりご紹介する場合があります。これらのご紹介を不要とされる場合、後述する電子メールアドレス の問合せ窓口にご連絡いただくことによって、以降のご紹介を行わないようにいたします。
お客様の個人情報の照会、訂正、削除につきましては、当社の問合せ窓口に、次の事項をご記入の上、ご本人からご連絡ください。
1)お名前
2)ご住所
3)ご連絡先電話番号
4)ご要請内容
制定日:2025年11月01日
株式会社 コーガアイソトープ



